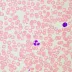
Mikroskop MAGUS Bio D260T LCD

Váš košík je prázdný
Ve vašem košíku aktuálně nic nemáte.
Přihlásit se
Ještě nemáte účet?
Registrovat se- Dalekohledy Zobrazit vše
-
Mikroskopy
Zobrazit vše
-
Monokuláry
-
Binokulární
-
Trinokulární
-
Školní / studentské
-
Laboratorní
-
Stereomikroskopy
-
Digitální
-
S kamerou / fotoaparátem
-
Bez kamery / fotoaparátu
-
Polarizační
-
Fluorescenční
-
Inverzní
-
Dark field mikroskopy
-
Metalurgické
-
USB mikroskopy
-
Biologické
-
Kapesní mikroskopy
-
Pro děti
-
Barevné
-
Prosvětlovací mikroskopy
-
Příslušenství k mikroskopům
-
- Noční vidění Zobrazit vše
- Fotopasti Zobrazit vše
- Termovize Zobrazit vše
- Lupy Zobrazit vše
- Laserové dálkoměry Zobrazit vše
- Dětská optika Zobrazit vše
- Foto, video Zobrazit vše
Mikroskop MAGUS Bio D260T LCD
Mikroskop je vhodný k pozorování průhledných a průsvitných biologických vzorků jako například stěrů a příčných řezů pomocí mikroskopické techniky světlého pole v procházejícím světle. Volitelné…
Více informací
Způsoby a ceny doručení
Zboží objednané do 14:00 odešleme ještě dnes
Doručení na adresu
Doručení na výdej místo
Nakupte ještě za 3 001 Kč a máte dopravu zdarma!
Sklad Tábor
Zboží je možné na výdejně v Táboře vyzvednout pouze po předchozím objednání na tomto e-shopu. Při příchodu na výdejnu prosím sdělte Vaše jméno a číslo objednávky.
380 427 584
Po-Pá: 10:00 - 16:00obchod@pozoruj.cz
Pozoruj.cz
Měšická 276
39002 Tábor
IČ: 28159233
DIČ: CZ28159233
Dotaz na dostupnost
- Značka:
- Magus
- Kategorie
- Mikroskopy
Popis a parametry
Mikroskop je vhodný k pozorování průhledných a průsvitných biologických vzorků jako například stěrů a příčných řezů pomocí mikroskopické techniky světlého pole v procházejícím světle. Volitelné příslušenství umožňuje použití mikroskopie v tmavém poli, fázového kontrastu, fluorescenční a polarizační mikroskopie. Kódovaný revolverový nosič objektivů udržuje při výměnách objektivů příjemnou úroveň jasu. Inteligentní systém ovládání osvětlení mikroskopu zvyšuje komfort a rychlost každodenní práce výzkumníka. Chytré funkce pomáhají studentům usnadnit vstup do profese a získat potřebné odborné zkušenosti. Mikroskop je vhodný pro laboratorní práci, výzkum a vzdělávání. Mikroskop je vybaven 8 Mpx fotoaparátem a třemi video rozhraními: HDMI, USB 2.0 a WLAN. Lze jej připojit současně k několika zařízením: monitoru, notebooku a stolnímu počítači. Software rozšiřuje systém o funkce pro analýzu a dokumentaci. Monitor digitálního mikroskopu má rozlišení 4K.
Digitální fotoaparát
MAGUS CHD50 je digitální HDMI fotoaparát s automatickým zaostřováním, který podporuje tři video rozhraní. Fotoaparát je vybaven 8 Mpx snímačem a vytváří realistické snímky v rozlišení 4K (3840x2160 px) s automatickým přepínáním mezi 4K a Full HD v závislosti na rozlišení monitoru. Fotoaparát disponuje rozhraním HDMI pro přímé připojení k televizoru, monitoru nebo projektoru. V tomto režimu pracuje fotoaparát samostatně bez počítače. Rozhraní HDMI poskytuje vysokou a stabilní rychlost přenosu z fotoaparátu na externí obrazovku. Fotoaparát můžete k počítači připojit prostřednictvím rozhraní WLAN nebo USB 2.0. Video se nahrává rychlostí 30 snímků za sekundu. Fotoaparát kombinuje vysoký počet snímků za sekundu a velkou šířku pásma HDMI, a proto jsou videa živá bez zamrzání nebo mezer mezi snímky. Při maximálním rozlišení produkt nabízí dobře prokreslený obraz, bezchybně se pohybující objekty a zobrazení bez zpožďování.
Monitor
Monitor MAGUS MCD40 je navržen pro použití s vizualizačními systémy mikroskopů MAGUS. Připojuje se k fotoaparátu namontovanému na mikroskopu a zobrazuje obraz v reálném čase. Je kompatibilní s fotoaparáty MAGUS HDMI pracujícími v rozlišení 4K. Úhlopříčka displeje je 13,3 palce. Snímač IPS poskytuje jasný obraz s velkými pozorovacími úhly: pokud se na monitor díváte pod úhlem, nedochází ke zkreslení barev. Displej lze umístit na skládací stojan na stole nebo jej přímo připevnit ke kameře podle toho, co je pro uživatele pohodlnější.
Hlavice mikroskopu
Trinokulární hlavice s optikou s korekcí na nekonečno. Tubusy okulárů jsou otočné o 360°. Uživatel si může nastavit výšku okulárů podle své postavy. Digitální fotoaparát je namontován v trinokulárním tubusu. Poměr rozdělení paprsku je pevně stanoven na 50/50. Svislý tubus nabízí zvětšení 0,55x. Ve spojení s dodaným adaptérem 1x je konečné zvětšení na fotoaparátu 0,55x. Při výběru fotoaparátu a výpočtu rozlišení a velikosti snímače použijte konečný faktor zvětšení 0,55x. Základní konfigurace obsahuje okuláry 10x/22 mm s dioptrickou korekcí a dlouhým očním reliéfem pro práci s brýlemi. Ploché gumové očnice chrání brýle před poškrábáním.
Revolverový nosič objektivů a objektivy
Kódovaný revolverový nosič pro pět objektivů je orientován směrem dovnitř: uživatel vidí objektiv zasunutý do optické dráhy a prostor nad pracovním stolkem je volný. Do volného slotu lze také nainstalovat přídavný objektiv pro dosažení většího zvětšení. Parfokální vzdálenost je 60 mm. Objektiv 40x s prodlouženou pracovní vzdáleností 1,5 mm poskytuje dodatečnou ochranu přední čočky před kontaktem s imerzním olejem při otáčení nosiče. Nad revolverovým nosičem je slot se zástrčkou pro analyzátor.
Udržování příjemné úrovně jasu při přepínání zvětšení
Objektivy různých zvětšení propouštějí světlo s různou úrovní intenzity, a proto je třeba při každé změně objektivu upravit jas světla. Při přepnutí z objektivu s vyšším zvětšením na objektiv s nižším zvětšením dochází k únavě očí, protože jas obrazu v okulárech se náhle zvýší. Model MAGUS Bio D260T LCD, vybavený inteligentní regulací jasu, tento problém řeší. Mikroskop si pamatuje jas pro každý objektiv, který uživatel zvolil, a automaticky jej nastaví při otáčení revolverového nosiče objektivů. Inteligentní ovládání zkracuje dobu potřebnou k nastavení jasu. Mikroskop MAGUS Bio D260T LCD zvyšuje uživatelský komfort a šetří čas i v případě, že práce vyžaduje časté změny zvětšení.
Mechanismus zaostřování
Koaxiální knoflíky pro hrubé a jemné ostření. Knoflík pro hrubé ostření je umístěn na levé straně. Knoflíky pro jemné ostření jsou umístěny na obou stranách, přičemž pravý knoflík má speciální vybrání pro prsty. Kroužkem na levé straně se nastavuje tuhost dráhy hrubého ostření. Uživatel si nastaví tuhost tak, aby se mu pohodlně pracovalo.
Pracovní stolek
Stolek nemá hřebenové vedení v ose X, což zlepšuje ergonomii. Mechanismus s řemenovým pohonem umožňuje plynulý pohyb preparátu. Držák preparátu je upevněn dvěma šrouby a lze jej při ručním skenování snadno vyjmout. Dlouhá ovládací rukojeť pracovního stolku zajišťuje uživatelský komfort při práci: vaše ruka může spočinout na stole, aniž by se namáhala.
Kondenzor
Kondenzor je výškově nastavitelný a lze jej vycentrovat. Typ montáže: s rybinovým držákem. Kroužkem kondenzoru se nastavuje aperturní clona. Tělo kondenzoru má označení pro zvětšení objektivů a kroužek má indikační značku. Pro dosažení kontrastu na každém objektivu se doporučuje otočit kroužkem tak, aby indexová značka odpovídala označení zvětšení použitého objektivu. Kondenzor má slot pro posuvník tmavého pole nebo posuvník fázového kontrastu. Instalace posuvníku šetří čas při změně pozorovací metody.
Zdroj světla
Osvětlovací soustava pro pozorování v procházejícím světle obsahuje 3 W LED diodu. Barevná teplota se při nastavení jasu nemění. Životnost LED diod je 50 000 hodin.
Köhlerovo osvětlení v procházejícím světle
Köhlerovo osvětlení zlepšuje kvalitu obrazu pozorovaného vzorku: každý objektiv dosahuje maximálního rozlišení a zorné pole je osvětleno rovnoměrně bez ztmavnutí na okrajích. Studovaný objekt je ostře zaostřený a artefakty obrazu jsou odstraněny.
Stavový LCD displej
LCD displej na základně mikroskopu zobrazuje zvětšení objektivu, jas a barevnou teplotu světelného zdroje a provozní režim ("sleep" – spánkový režim, "eco" – úsporný režim). Pomocí obrazovky a dvou knoflíků uživatel mikroskopu nastavuje jas, aretuje polohu nastavení jasu a nastavuje režim spánku a časovač automatického vypnutí.
Ergonomický design
Fyzické nepohodlí způsobuje únavu a snižuje produktivitu. Ergonomický design mikroskopu hraje důležitou roli v každodenním vědeckém výzkumu. Mikroskop MAGUS Bio D260T LCD poskytuje uživatelský komfort při práci. Otáčením hlavice mikroskopu si uživatel volí výšku zorného úhlu tak, aby si nenamáhal záda a krk. Zaostřovací knoflíky jsou umístěny ve spodní části těla mikroskopu. Uživatel si tak nemusí namáhat ruce. Díky plynulému pohybu mechanismu může uživatel bez námahy zaostřit na objekt. Mikroskop se ovládá s minimálním pohybem ruky, protože dlouhá ovládací rukojeť pracovního stolku a knoflík pro jemné zaostřování jsou umístěny ve stejné pracovní oblasti. Mikroskop je vybaven speciální rukojetí pro přenášení. Konstrukce pro skryté umístění napájecího kabelu zlepšuje estetiku pracoviště a bezpečnost při přenášení mikroskopu a také usnadňuje skladování přístroje.
Příslušenství
K dispozici je řada příslušenství navržená speciálně pro tento mikroskop. Volitelné objektivy poskytují další zvětšení. Okuláry rozšiřují rozsah zvětšení mikroskopu. Volitelné okuláry vám pomohou maximalizovat potenciál objektivu, který používáte nejčastěji. Zařízení s fázovým kontrastem, epifluorescenční nástavec, posuvník tmavého pole a sada pro polarizátor/analyzátor nabízejí více kontrastních technik, takže můžete studovat preparáty, které jsou ve světlém poli neviditelné. K měření objektů se používá kalibrační sklíčko, které lze kombinovat s okulárem se stupnicí nebo se softwarem fotoaparátu.
Alternativní modely
MAGUS Bio D260T LCD je alternativou pro následující modely: Carl Zeiss Primostar 3, Leica DM 1000, Leica DM 1000LED, Leica DM 2000, Leica DM 2000LED, Olympus CX 33.
Vlastnosti mikroskopu:
- Pozorování průhledných a průsvitných vzorků ve světlém poli v procházejícím světle
- Trinokulární hlava s vertikálním tubusem pro instalaci digitálního fotoaparátu a výškovým nastavením pro přizpůsobení pozorovateli; rozdělení světelného paprsku 50/50
- Kódovaný revolverový nosič objektivů: jas světelného zdroje se nastavuje automaticky v závislosti na zvoleném objektivu
- Osvětlovací soustava pro pozorování v procházejícím světle je energeticky úsporné 3 W LED světlo s životností až 50 000 hodin
- Köhlerovo osvětlení v procházejícím světle, vystředěný a výškově nastavitelný kondenzor s označením zvětšení objektivu
- Inteligentní systém ovládání osvětlení: automatická volba jasu, aretace polohy nastavení stmívání, časovač automatického vypnutí, LCD obrazovka provozního stavu
- Pracovní stolek bez polohovacího stojanu v ose X a s dlouhou ovládací rukojetí pro pohodlné ovládání
- Ergonomický stojan s rukojetí pro přenášení a skrytým umístěním napájecího kabelu
- Široká škála kompatibilního volitelného příslušenství
Funkce fotoaparátu:
- Fotoaparát pracuje samostatně prostřednictvím rozhraní HDMI bez nutnosti připojení k počítači nebo instalace softwaru. K počítači se může připojit také prostřednictvím WLAN a rozhraní USB 2.0.
- Automatické zaostřování v režimu HDMI usnadňuje nastavení ostrosti obrazu
- Automatické přepínání mezi rozlišením 4K a Full HD v závislosti na rozlišení monitoru
- 30 snímků za sekundu s libovolným výstupním rozhraním videa pro pozorování pohybujících se objektů, nahrávání videa a pohyb vzorku bez trhání nebo zpoždění
- Barevný CMOS snímač SONY Exmor/Starvis s podsvícením zajišťuje nízkou úroveň šumu a vysokou citlivost na světlo i za špatných světelných podmínek. Získáte jasnější, čistší a barevně sytější snímky
- Software s funkcemi fotografování, záznam videa, střihu, zobrazení na externím monitoru a lineárního a úhlového měření
Funkce monitoru:
- Rozlišení 4K poskytuje vysoce detailní, jasný a realistický obraz
- Snímač IPS poskytuje jasný a sytý obraz s širokými vertikálními a horizontálními pozorovacími úhly
- Lze připevnit na fotoaparát nebo na stůl podle přání uživatele
Obsah sady:
- Digitální fotoaparát MAGUS CHD50 (digitální fotoaparát, kabel HDMI (1,5 m), kabel USB 2.0 (1,5 m), myš USB, paměťová karta SD 32 GB, napájecí adaptér 12 V/1 A (Euro), paměťové zařízení s ovladači a softwarem, návod k použití a záruční list)
- LCD monitor MAGUS MCD40
- Stojan s vestavěným napájecím zdrojem, zdrojem procházejícího světla, zaostřovacím mechanismem, pracovním stolkem, držákem kondenzoru a revolverovým nosičem objektivů
- Abbeův kondenzor
- Hlavice trinokulárního mikroskopu
- Planachromatický objektiv Plan 4x/0,10 ∞/–, parfokální vzdálenost: 60 mm
- Planachromatický objektiv Plan 10x/0,25 ∞/–, parfokální vzdálenost: 60 mm
- Planachromatický objektiv Plan 40x/0,65 ∞/0,17, parfokální vzdálenost: 60 mm
- Planachromatický objektiv Plan 100x/1,25 olej ∞/0,17 (odpružený), parfokální vzdálenost: 60 mm
- Okulár 10x/22 mm s dlouhým očním reliéfem a dioptrickou korekcí (2 ks)
- Očnice (2 ks)
- Adaptér typu C-mount
- Napájecí kabel mikroskopu
- Protiprachový kryt
- Návod k použití a záruční list
K dispozici na přání:
- 10x/22 mm okulár se stupnicí
- 10x/22 mm okulár s optickou mřížkou
- 10x/22 mm okulár s nitkovým křížem
- 12,5x/16 mm okulár (2 ks)
- 15x/16 mm okulár (2 ks)
- 20x/12 mm okulár (2 ks)
- 30x/8 mm okulár (2 ks)
- Planachromatický objektiv Plan 2x/0,06 ∞/–, parfokální vzdálenost: 60 mm
- Planachromatický objektiv Plan 20x/0,40 ∞/0,17, parfokální vzdálenost: 60 mm
- Planachromatický objektiv Plan 60x/0,80 ∞/0,17, parfokální vzdálenost: 60 mm
- Planachromatický objektiv Plan Apo 60x/1,42 olej ∞/0,17, parfokální vzdálenost: 60 mm
- Planachromatický objektiv Plan 100x/1,10 ∞/0,17 voda, parfokální vzdálenost: 60 mm
- Sada rovinných poloapochromatických fluorescenčních objektivů: 4x, 10x, 20x, 40x, 100x (olej); ∞/0,17; parfokální vzdálenost 60 mm
- Zařízení pro fázový kontrast: sada fázových posuvníků, sada fázových objektivů, pomocný centrovací dalekohled
- Zařízení pro fázový kontrast: kondenzor pro fázový kontrast, sada fázových objektivů, pomocný centrovací dalekohled
- Posuvník tmavého pole
- Kondenzor pro pozorování v tmavém poli pro suché objektivy NA 0,7–0,9
- Kondenzor pro pozorování v tmavém poli s olejovou imerzí NA 1,3–1,26
- Epifluorescenční nástavec se zdrojem světla LED, kostkami fluorescenčních filtrů a napájecím kabelem
- Sada polarizátoru/analyzátoru
- Digitální fotoaparát
- Kalibrační sklíčko
- Sada barevných filtrů (modrý, zelený, žlutý, matné sklo)
- Adaptér typu C-mount
| Značka | MAGUS |
| Záruka | 5 let |
| EAN | 5905555019918 |
| Velikost balení (DxŠxV) | 47x32x67 cm |
| Přepravní hmotnost | 15.05 kg |
| Typ | biologický, světlo / optické |
| Typ hlavy mikroskopu | trinokulární |
| Hlava | Gemelova hlava (Seidentopf, otočná o 360°), s 50/50 distribucí světelného toku |
| Úhel sklonu hlavy | 30° |
| Zvětšení, x | 40 — 1000 |
| Rozsah zvětšení | od 800x do 1280x |
| Zvětšení, x (volitelné) | 40–1250/1500/2000 |
| Průměr tubusu okuláru v mm | 30 |
| Okuláry | 10x/22, dlouhý oční reliéf (*volitelně: 10x/22 se stupnicí, 10x/22 s optickou mřížkou, 10x/22 s nitkovým křížem, 12,5x/16, 15x/16, 20x/12, 30x/8) |
| Objektivy | rovinné achromatické: 4x/0,10; 10x/0,25; 40x/0,65; 100x/1,25 olej (*volitelně: 2x/0,06; 20x/0,40; 60x/0,80; 100x/1,10 voda; Plan Apo 60x/1,42 olej, sada rovinných poloapochromatických fluorescenčních objektivů 4x/10x/20x/40x/100x olej); parfokální výška 60 mm |
| Revolverový nosič | 5 objektivy, kódovaný |
| Pracovní vzdálenost, mm | 30 (4x); 10,2 (10x); 1,5 (40x); 0,2 (100xs) |
| Mezipupilární vzdálenost (IPD), mm | 47 — 78 |
| Stolek, mm | 230x150 |
| Zdvih stolku pomocí zaostřovacího mechanismu, mm | 78/54 |
| Pracovní stolek, mm | dvouosý mechanický stolek, bez polohovacího stojanu |
| Dioptrická korekce okuláru, dioptrií | ±5D na každém okuláru |
| Dioptrická korekce okuláru | yes |
| Kondenzor | středově a výškově nastavitelný Abbeův kondenzor NA 1,25 s nastavitelnou aperturní clonou a slotem se zástrčkou pro posuvník tmavého pole a posuvník fázového kontrastu; rybinový držák |
| Clona | nastavitelná aperturní clona, nastavitelný kondenzor s irisovou clonou |
| Zaostření | koaxiální, hrubé ostření (30 mm, 37,7 mm/kruh, s mechanismem pro nastavení tuhosti) a jemné ostření (0,002 mm, 0,2 mm/kruh) |
| S osvětlením | LED |
| Regulace jasu | yes |
| Napájení | 100–240 V, 50/60 Hz, AC síť |
| Typ světelného zdroje | 3 W LED |
| Rozsah provozní teploty, °C | 0 — 70 |
| Další vlastnosti | automatické nastavení jasu při přepínání objektivů, režim spánku, zobrazení stavu na LCD obrazovce, úsporný režim |
| Možnost připojení dalších zařízení | epifluorescenční nástavec, kondenzor tmavého pole (pro suché objektivy nebo olejovou imerzi), polarizační zařízení (polarizátor a analyzátor), posuvník tmavého pole, zařízení fázového kontrastu (kondenzor a objektivy), zařízení fázového kontrastu (posuvník a objektivy) |
| Typ uživatele | profesionálové, zkušení uživatelé |
| Možnosti použití | laboratorní/lékařská |
| Umístění světelného zdroje | spodní |
| Metody pozorování | světlé pole |
| Pouzdro/kufřík/taška v sadě | protiprachová ochrana |
| Snímač | Sony Exmor/Starvis CMOS |
| Barevný/černobílý | barevný |
| Megapixely | 8 |
| Maximální rozlišení, px | 3840x2160 (4K UHD) |
| Velikost snímače | 1/1,8" (7,68x4,32 mm) |
| Rozměr pixelu, mkm | 2x2 |
| Automatické zaostřování | yes |
| Konektory rozhraní | HDMI 1.4, WLAN, USB 2.0 |
| Paměťová karta | SD až 32 GB |
| Citlivost na světlo | 505 mV při 1/30 s |
| Poměr signálu k šumu | 0,15 mV při 1/30 s |
| Expoziční čas | 0,04 ms – 1000 ms |
| Záznam videa | yes |
| Snímková frekvence, fps (počet snímků za sekundu) při rozlišení | 30 při rozlišení 3840x2160 (HDMI), 30 při rozlišení 3840x2160 (USB), 30 při rozlišení 3840x2160 (WLAN) |
| Místo montáže | trinokulární tubus, okulárový tubus namísto okuláru |
| Obrazový formát | *.jpg, *.tif |
| Spektrální rozsah, nm | 380–650 (vestavěný IR filtr) |
| Typ závěrky | ERS (Electronic Rolling Shutter – elektronická rolovací závěrka) |
| Software | HDMI: vestavěné; USB: MAGUS View |
| Systémové požadavky | Windows 8/10/11 (32 bit a 64 bit), Mac OS X, Linux, až 2,8 GHz Intel Core 2 nebo vyšší, minimálně 4 GB RAM, port USB 2.0, RJ45, 19" nebo větší displej |
| Typ montáže | C-mount |
| Tělo | CNC slitina hliníku |
| Napájení fotoaparátu | DC adaptér 12 V, 1 A |
| Specifikace napájecího adaptéru DC | vstup: napětí AC 100–240 V, 50/60 Hz, výstup: napětí DC 12 V/1 A |
| Rozsah provozních teplot fotoaparátu, °C | -10 — 50 |
| Rozsah provozní vlhkosti, % | 30 — 80 |
| Typ matrice | IPS |
| Úhlopříčka displeje, palce | 13.3 |
| Rozlišení displeje, px | 3840x2160 (4K) |
| Poměr stran | 16:9 |
| Jas, cd/m² | 400 |
| Počet zobrazovaných barev | 16,7 m |
| Kontrast | 1000:1 |
| Horizontální/vertikální pozorovací úhel, ° | 178/178 |
| Velikost viditelné plochy obrazovky (ŠxV), mm | 295x165 |
| Rozteč pixelů (ŠxV), mm | 0,154x0,154 |
| Frekvence optického zdroje, Hz | 60 |
| Typ matrice podsvícení | LED |
| Životnost podsvícení LED, h | 50000 |
| Rozhraní | HDMI |
| Rozsah provozní teploty, °C | -15 — 55 |
| Rozsah provozní vlhkosti, % | 10 — 90 |
| Napájení | AC 110–220 V, DC 5–12 V/1 A (Type-C) |
| Spotřeba elektrické energie, W | 12 (max.) |
Potřebujete poradit?
Potřebujete poradit?
Jsem připraven vám pomoci
Potřebujete poradit?
Recenze zákazníků (0)
Recenze zákazníků (0)
Produkt zatím nikdo nehodnotil, buďte první!
Recenze mohou přidávat pouze zákazníci, kteří zakoupili produkt.
Dotazy zákazníků (0)
Dotazy zákazníků (0)
Dotaz na produktChcete se na něco zeptat? Napište nám to.
Tento produkt nemá zatím žádný dotaz.
Dotaz na produkt Mikroskop MAGUS Bio D260T LCD
Ceny držíme na uzdě
Našli jste jinde lepší cenu? Potřebujete poradit?
4 806 produktů skladem
Kvalitu držíme vysoko. Expedujeme rychle.
Nad 3 000 Kč doprava zdarma
20 tisíc výdejních míst po celé ČR
100 % zákazníků nás doporučuje
Zlaté ověřeno zákazníky mluví za vše
-
100 % zákazníků náš obchod doporučuje
Nadprůměrná spokojenost zákazníků nám zajistila certifikát Ověřeno
-
Obchod jsem neznala a tak jsem byla opatrná, takže jsem zvolila placení na dobírku. Můžu ale potvrdit, že se jedná o důvěryhodný obchod a vše proběhlo v pořádku. K mému překvapení…
Ověřený uživatel před 4 měsíci
-
Kvalitní sortiment, dobrá komunikace
Ověřený uživatel před 5 měsíci
-
Kvalitní popis nabízeného zboží, jednoduché objednání, rychlé dodání a kvalitní zabalení výrobku.
Ověřený uživatel před 6 měsíci
Zákaznický servis
Oblíbené kategorie
380 427 584
Po-Pá: 10:00 - 16:00obchod@pozoruj.cz
Pozoruj.cz
Měšická 276
39002 Tábor
Česká Republika
Provozovatel: Alemat.cz, spol. s r.o.
IČ: 28159233
DIČ: CZ28159233
Možnosti doručení:
Platební metody:
Převodem
Na fakturu
Dobírka